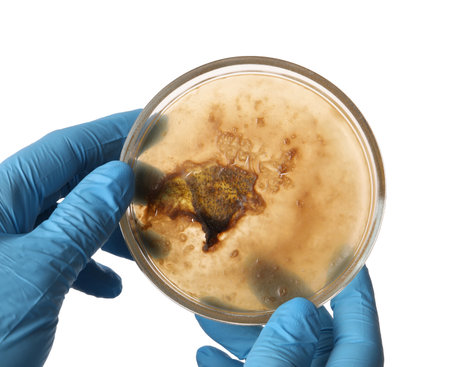
Laboratory worker holding petri dish with bacteria on white background, closeupの写真素材

写真素材 - Laboratory worker holding petri dish with bacteria on white background, closeup
作品情報
Laboratory worker holding petri dish with bacteria on white background, closeup
- ID:236240026
- 作品種別:写真
- 作者名:liudmilachernetska
キーワード
- analysis
- antimicrobial
- background
- bacteria
- bacteriology
- bacterium
- biochemistry
- biology
- biotechnology
- brown
- chemical
- clinical
- closeup
- colony
- disease
- dish
- equipment
- experiment
- female
- fluid
- glass
- glassware
- hand
- holding
- industry
- infectious
- isolated
- lab
- laboratory
- liquid
- medical
- medicine
- microbiology
- microorganism
- mycobacterium
- person
- petri
- pharmaceutical
- reagent
- research
- sample
- science
- study
- test
- texture
- virus
- white
- woman
- worker
類似作品
A scientist in ...
scientist worki...
Blurred of red ...
close up of han...
A lab technicia...
scientist worki...
scientist worki...
Doctor in blue ...
Blood test in t...
Young woman sci...
Health care res...
Science technic...
professional ch...
Bioarcheology. ...
Scientist holdi...
A precision eng...
Professional sc...
Scientist holdi...
female research...
scientist worki...
Medical doctor ...
a doctor in a w...
Medical doctor ...
Lab technician ...
Scientist holdi...
Researchers wor...
medical marijua...
Researchers wor...
A dedicated sci...
professional ch...
Young scientist...
scientist worki...
Doctor with syr...
Wearing white c...
Tablet, innovat...
scientist worki...
hands of a scie...
Ensuring Labora...
Team of medical...
One of the labo...
A worker in a p...
Female laborato...
Group of dedica...
A healthcare pr...
Blood test in t...
Testing water q...
scientist worki...
Work in the Pha...
Researchers wor...